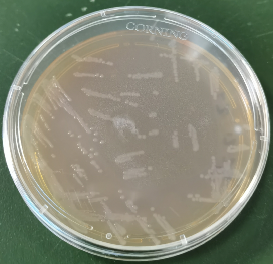

猪粪便来源乳酸菌分离技术
Separation Protocol for Fecal Lactobacillus bacteria in Swine
李云霞,夏嗣廷,马杰,韩琦,龚赛明,黄兴国,尹杰*
湖南农业大学动物科学技术学院,动物营养基因组与种质创新研究中心,长沙,410128
*通讯作者邮箱:yinjie2014@126.com
引用格式:李云霞, 夏嗣廷, 马杰, 韩琦, 龚赛明, 尹杰. (2021). 猪粪便来源乳酸菌分离技术. // 微生物组实验手册. Bio-101: e2104029. DOI: 10.21769/BioProtoc.2104029.
How to cite: Yunyun Gao, Kai Peng, Defeng Bai, et al. 2024. The Microbiome Protocols eBook initiative: Building a bridge to microbiome research. iMeta 3: e182. https://doi.org/10.1002/imt2.182
摘要:微生物分离技术是根据微生物的特性和生长特点,模拟微生物的生态环境,以不同的培养基和培养条件对微生物进行分离、纯化的过程。乳酸菌是目前研究最热的益生菌之一,然而,益生菌菌株的益生功能具有宿主种的差异性和菌株特异性,菌株的鉴定对菌种与其特殊益生作用建立联系十分重要。MRS培养基中的乙酸钠和柠檬酸铵等作为选择剂,对革兰氏阴性细菌和霉菌有抑制作用,十分适于乳酸菌的生长,是分离培养乳酸菌的一种常用的培养基。本文将借鉴人类医学及哺乳动物中现有的微生物分离的技术手段与方法,以宁乡猪为范例阐述猪粪便来源乳酸菌分离技术。
关键词:猪,乳酸菌,分离培养
材料与试剂
1.MRS琼脂(青岛海博生物技术有限公司)
2.MRS肉汤(青岛海博生物技术有限公司)
3.生理盐水
4.各种型号枪头
5.甘油(美仑生物技术有限公司)
6.无菌离心管(corning)
7.涂布棒
8.接种环
9.培养皿
仪器设备
1.高压灭菌锅
2.离心机
3.-80 °C冰箱
4.涡旋振荡器
5.恒温培养箱
6.组合振荡培养箱
7.移液器
8.电子天平
9.超净工作台
实验步骤
1.采集健康宁乡猪的新鲜粪便,装入50 ml无菌离心管中,放入冰盒,立即带回实验室进行细菌分离。
2.称取1 g粪便,装入无菌试管中,再加入9 ml的无菌生理盐水,放置于振荡器上充分震荡,使样品充分混匀,静置5 min,即为10-1的样品液。
3.取1 ml 10-1的样品液,用无菌生理盐水进行10倍梯度稀释。
4.分别取10-2-10-7稀释梯度的稀释液200μl,涂布到MRS琼脂培养基上(图1)。置于37℃恒温培养箱中培养24-48 h。
5.待单菌落出现(图2a),从MRS琼脂板上挑取形态各异的单个菌落,在新的MRS琼脂板上划线,37 ℃培养24 h,进行菌株的纯化。
6.重复纯化3-4次,直至得到纯菌落(图2b)。
7.培养获得的乳酸菌,进行16S rDNA测序。并将菌液和50%的灭菌甘油等体积混匀(1:1)后放入-80度冰箱保存。

图1.分离纯化过程

图2.分离(a)和纯化(b)所得乳酸菌菌落
注意事项
1.应收集新鲜粪便制作粪便菌液。
2.制作粪便菌液过程中使用的设备容器都应做灭菌处理。
3.操作台应提前灭菌。
4.琼脂培养基:MRS琼脂培养基用于筛选、短期保存。
5.液体培养基:MRS液体培养基用于活化、扩大培养等。
6.试验过程中接种环、涂布棒在灼烧灭菌后,需冷却后再进行操作。
致谢
感谢中国科协青年人才托举工程(2019-2021QNRC001)和湖南省杰出青年基金(2020JJ3023)的支持。
参考文献
1.He T, Zhu YH, Yu J, Xia B, Liu X, Yang GY, Su JH, Guo L, Wang ML, Wang JF. Lactobacillus johnsonii L531 reduces pathogen load and helps maintain short-chain fatty acid levels in the intestines of pigs challenged with Salmonella enterica Infantis. Vet Microbiol. 2019 Mar;230:187-194. doi: 10.1016/j.vetmic.2019.02.003. Epub 2019 Feb 5. PMID: 30827387.
2.Kaur M, Singh H, Jangra M, Kaur L, Jaswal P, Dureja C, Nandanwar H, Chaudhuri SR, Raje M, Mishra S, Pinnaka AK. Lactic acid bacteria isolated from yak milk show probiotic potential. Appl Microbiol Biotechnol. 2017 Oct;101(20):7635-7652. doi: 10.1007/s00253-017-8473-4. Epub 2017 Sep 6. PMID: 28879447.
3.Jose NM, Bunt CR, Hussain MA. Comparison of Microbiological and Probiotic Characteristics of Lactobacilli Isolates from Dairy Food Products and Animal Rumen Contents. Microorganisms. 2015 Apr 15;3(2):198-212. doi: 10.3390/microorganisms3020198. PMID: 27682086; PMCID: PMC5023236.
4.Verdenelli MC, Ghelfi F, Silvi S, Orpianesi C, Cecchini C, Cresci A. Probiotic properties of Lactobacillus rhamnosus and Lactobacillus paracasei isolated from human faeces. Eur J Nutr. 2009 Sep;48(6):355-63. doi: 10.1007/s00394-009-0021-2. Epub 2009 Apr 14. PMID: 19365593.
5.Yan F, Li N, Yue Y, Wang C, Zhao L, Evivie SE, Li B, Huo G. Screening for Potential Novel Probiotics With Dipeptidyl Peptidase IV-Inhibiting Activity for Type 2 Diabetes Attenuation in vitro and in vivo. Front Microbiol. 2020 Jan 10;10:2855. doi: 10.3389/fmicb.2019.02855. PMID: 31998245; PMCID: PMC6965065.
宏基因组推荐
本公众号现全面开放投稿,希望文章作者讲出自己的科研故事,分享论文的精华与亮点。投稿请联系小编(微信号:yongxinliu 或 meta-genomics)
猜你喜欢
iMeta高引文章 fastp 复杂热图 ggtree 绘图imageGP 网络iNAP
iMeta网页工具 代谢组MetOrigin 美吉云乳酸化预测DeepKla
iMeta综述 肠菌菌群 植物菌群 口腔菌群 蛋白质结构预测
10000+:菌群分析 宝宝与猫狗 梅毒狂想曲 提DNA发Nature
一文读懂:宏基因组 寄生虫益处 进化树 必备技能:提问 搜索 Endnote
16S功能预测 PICRUSt FAPROTAX Bugbase Tax4Fun
生物科普: 肠道细菌 人体上的生命 生命大跃进 细胞暗战 人体奥秘
写在后面
为鼓励读者交流快速解决科研困难,我们建立了“宏基因组”讨论群,己有国内外6000+ 科研人员加入。请添加主编微信meta-genomics带你入群,务必备注“姓名-单位-研究方向-职称/年级”。高级职称请注明身份,另有海内外微生物PI群供大佬合作交流。技术问题寻求帮助,首先阅读《如何优雅的提问》学习解决问题思路,仍未解决群内讨论,问题不私聊,帮助同行。
点击阅读原文
























 被折叠的 条评论
为什么被折叠?
被折叠的 条评论
为什么被折叠?








